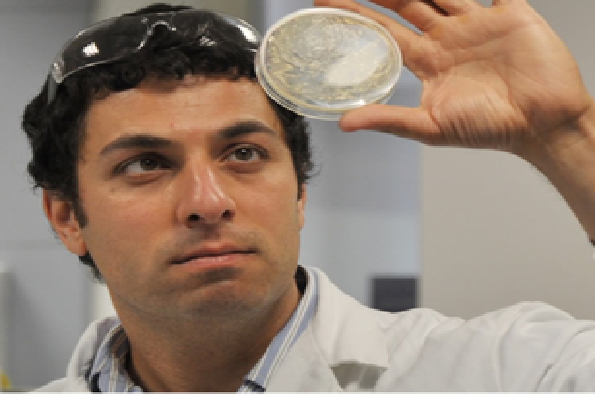
Ali

A Platform for Generating and Screening Cyclic Peptide Libraries of Over a Hundred Million Members for Protein-Protein Interaction Inhibitors - Ali Tavassoli (University of Southampton)
- Pat Eyers
- Suitable for: University of Liverpool Staff and Students
- Admission: No cost
Add this event to my calendar
Click on "Create a calendar file" and your browser will download a .ics file for this event.
Microsoft Outlook: Download the file, double-click it to open it in Outlook, then click on "Save & Close" to save it to your calendar. If that doesn't work go into Outlook, click on the File tab, then on Open & Export, then Open Calendar. Select your .ics file then click on "Save & Close".
Google Calendar: download the file, then go into your calendar. On the left where it says "Other calendars" click on the arrow icon and then click on Import calendar. Click on Browse and select the .ics file, then click on Import.
Apple Calendar: The file may open automatically with an option to save it to your calendar. If not, download the file, then you can either drag it to Calendar or import the file by going to File >Import > Import and choosing the .ics file.
The main focus of the Tavassoli lab is the identification of cyclic peptide inhibitors of protein-protein interaction using a genetically encoded high-throughput screening platform. The goal is the development of compounds capable of disrupting the association and assembly of protein complexes. The compounds uncovered serve as valuable tools that allow better understanding of the role of individual protein-protein interactions in cells. These compounds also form the starting point for the development of therapeutic compounds that target key protein-protein interactions in disease. Research is focused on training scientists at the chemistry-biology interface, and using these interdisciplinary skills to help understand the fundamentals of cell biology and to develop new therapeutic agents.
